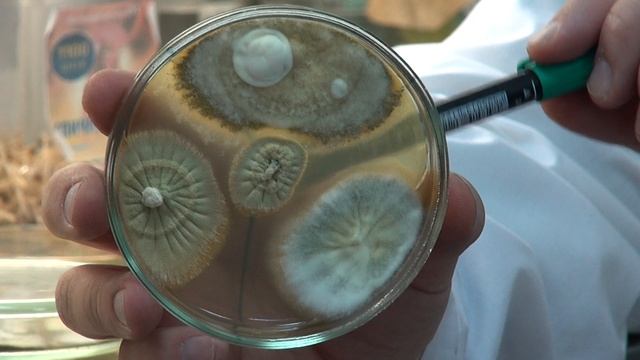
ГРИБЫ МЕТАРИЗИУМ || Взаимодействие различных видов и штаммов между собой смотреть онлайн

Автор: Строительное Искусство Страница 2

Посылки из Китая. Удлинители наушников, PH-metter, супер-фонарь. Распаковка и обзор.

Металлокассеты для фасада.
ГРИБЫ МЕТАРИЗИУМ || Взаимодействие различных видов и штаммов между собой

49 Вывод документов на печать

ДРЕВНИЕ ТЕХНОЛОГИИ СТРОИТЕЛЬСТВА В РУССКОМ СЕЛЕ/ANCIENT CONSTRUCTION TECHNOLOGIES IN RUSSIAN VILLAG

Нихромовая спираль 12В 4А 3Ом

Плесень в цветочном горшке Орхидея фаленопсис Чем опасна плесень для орхидей?

Где купить пульт Дексп Dexp в Минусинске

#Ленточная пила "Зубр" 2.5 года в эксплуатации
![Русская глубинка прекрасна! [прогулка на коне по полю с коровами] смотреть онлайн](https://pic.rutubelist.ru/video/3a/7f/3a7f3ce30481565271a5488667e4b4c1.jpg?size=m)
Русская глубинка прекрасна! [прогулка на коне по полю с коровами]

Отделка трехкомнатной квартиры 103 кв.м "под ключ" в новостройке, Заречье

СОДЕРЖАНИЕ МЕСЯЧНЫХ ИНДЮШАТ на полу//ЧЕМ МЫ КОРМИМ МОЛОДНЯК?//деревенские будни

Фундаментные блоки в 35 масштабе

Разбор проекта освещения в DIALux EVO для квартиры 140 квадратных метров в Москве

Allelopathy in agriculture | Allelopathy in plants in hindi | Management of Allelopathy

Обзор сортов томатов на сезон 2023. Часть 2

Боевое развертывание от прицепной мотопомпы МП-1600

В Советском районе придумали, как усовершенствовать окопные свечи

Королева Анна Картофель Описание Сорта

Чем удобрять газон ✔️ Подкормка газонных трав весной

Skracanie starych tui brabant nożycami husqvarna 530iP4 520iHE3

Бюджетный квадроцикл- рама

Светодиодный прожектор с датчиком движения SUPRA SL-FL-SEN-20W(10W)/4000K-SE

Подиум в душевой без бортика в процессе
За каждым успешным каналом стоит личность, идея и сотни часов кропотливого труда. Если вы здесь, значит, автор «Строительное Искусство» уже сумел зацепить ваше внимание своим уникальным стилем или подачей. А мы на RUVIDEO позаботились о том, чтобы вы могли изучить весь архив его работ в максимально комфортных условиях — без лишней суеты и преград.
Почему за работами канала «Строительное Искусство» так интересно наблюдать? Всё просто: это честный контент, который находит отклик в сердцах зрителей. На нашем ресурсе вы можете смотреть онлайн все видео любимого автора бесплатно и в хорошем качестве. Нам важно, чтобы вы видели каждую деталь и слышали каждый нюанс, поэтому мы используем только стабильные плееры из открытых источников Rutube.
Следите за новинками канала, пересматривайте старые шедевры и открывайте для себя новые грани творчества «Строительное Искусство». Мы постоянно обновляем ленту, чтобы у вас под рукой всегда были самые свежие выпуски. Никаких сложных регистраций — только вы и творчество, которое вдохновляет. Приятного вам путешествия по миру авторского контента на RUVIDEO!
Видео взято из открытых источников Rutube. Если вы правообладатель, обратитесь к первоисточнику.